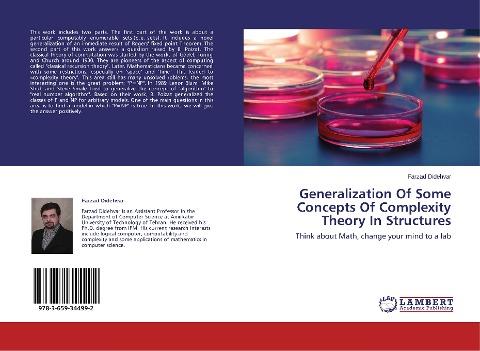
Generalization Of Some Concepts Of Complexity Theory In Structures

Autorenfreundlich Bücher kaufen?!

Beschreibung
This work includes two parts. The first part of the work is about a particular computably enumerable sets (c.e. sets). It includes a novel generalization of an immediate result of Rogers' fixed point Theorem. The second part of this work answers a question raised by B. Poizat. The classical theory of computation was started by the works of Gödel, Turing and Church around 1930. They are pioneers of the aspect of computing called "classical recursion theory". Later, Mathematicians became concerned with some restrictions, especially on "space" and "time". This leaded to «complexity theory". This area still has many unsolved roblems, the most interesting one is the great problem: "P=NP". In 1989 Lenor Blum, Mike Shub and Steve Smale tried to generalize the concept of "algorithm" to "real number algorithm". Based on their work, B. Poizat generalized the classes of P and NP for arbitrary models. One of the main questions in this area is to find a model in which "P=NP" is true. In this work, we will give the answer positively.
Think about Math, change your mind to a lab
Details
| Verlag | LAP LAMBERT Academic Publishing |
| Ersterscheinung | 05. August 2014 |
| Maße | 22 cm x 15 cm x 0.6 cm |
| Gewicht | 131 Gramm |
| Format | Softcover |
| ISBN-13 | 9783659344992 |
| Seiten | 76 |